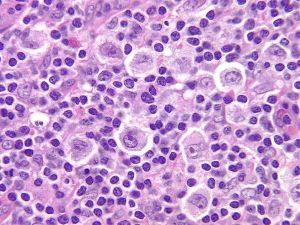
R-S細胞

細胞形態
r-s細胞該細胞一般見於淋巴瘤患者骨髓象塗片,又叫里-斯細胞。
診斷方式
血液:血象變化較早,常有輕或中等貧血,偶伴抗人球蛋白試驗陽性,少數白細胞輕度或明顯增加,伴中性粒細胞增多。約1/5患者嗜酸粒細胞升高。晚期淋巴細胞減少。骨髓被廣泛浸潤或發生脾功能亢進時,可有全血細胞減少。疾病活動期有血沉增速,血清乳酸脫氫酶活力增高,α球蛋白及結合珠蛋白及血漿銅藍蛋白增多。當血清鹼性磷酸酶活力或血鈣增加,提示骨骼累及。
骨髓:大多為非特異性。如能找到里-斯細胞對診斷有助。里-斯細胞大小不一,約20μm-60μm,多數較大,形態極不規則。胞漿嗜雙色性,核外形不規則,可呈“鏡影”狀,也可多葉或多核,偶有單核,核染質粗細不等,核仁可大達核的1/3。結節硬化型HD中里-斯細胞由於變形,漿濃縮,兩細胞核之間似有空隙,稱為腔隙型里-斯細胞。浸潤大多由血源播散而來,骨髓穿刺塗片陽性率僅3%,但活檢法可提高至9%~22%,用以探索骨髓轉移,意義較大。
胸部及縱隔X線斷層攝片:可發現肺門淋巴結腫大和肺部浸潤。
下腔靜脈造影和靜脈腎盂造影:前者可發現第二腰椎以上主動脈旁腫大的淋巴結,後者可顯示輸尿管是否移位,此外做腹部放療時需了解腎臟位置。
雙足淋巴管造影(pedallymphogram):可早期發現腹腔和主動脈旁淋巴結腫大。
分類
里-斯氏細胞可分為兩大類:
診斷性R-S細胞
診斷性里-斯氏細胞
R-S細胞的變種
又可分為三型:
①腔隙型里-斯氏細胞,常在結節硬化型中出現;
②多倍性里-斯氏細胞,常見於淋巴細胞耗竭型;
③多形性里-斯氏細胞,也多見於淋巴細胞耗竭型。
臨床意義
Hodgkin’slymphoma(霍奇金淋巴瘤)的致病細胞。